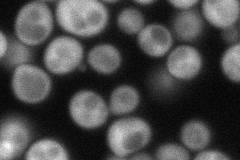
YNL023C
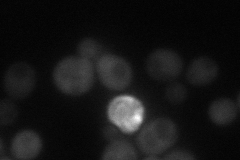
YNL023C
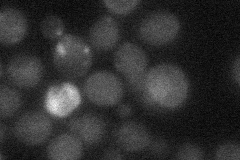
YNL023C
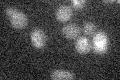
YNL023C

View description
Protein that binds to Fpr1p, conferring rapamycin resistance by competing with rapamycin for Fpr1p binding; accumulates in the nucleus upon treatment of cells with rapamycin; has similarity to D. melanogaster shuttle craft and human NFX1
Localization:
Intensity:
Fold change:
Significance:
-
C’ GFP library in SD

below threshold16.3 -
N' NOP1pr-GFP in SD
cytosol99.1852 -
N' TEF2pr-mCherry in SD
cytosol45.7366 -
N' NATIVEpr-GFP in SD
below threshold19.3023 -
N' TEF2pr-VC and Cyto-VN in SD

cytosol40.1246 -
C’ GFP library in SD+DTT

cytosol16.621.01No -
C’ GFP library in SD+H2O2

cytosol17.141.05No -
C’ GFP library in Starvation Media
cytosol15.090.92No -
C’ GFP library on the background of Pup2-DaMP

below threshold -
C’ GFP library on the background of CCT mutant

below threshold17.58821.07814No
